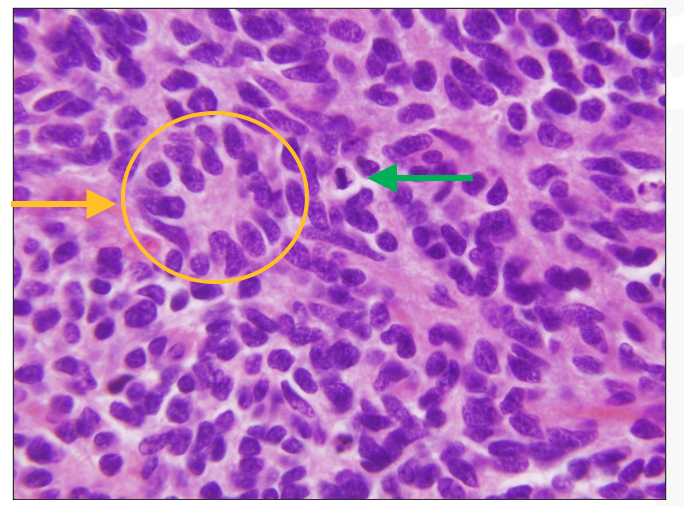

label these


Whats the arrow pointing to and where is it located

ependymal cells in ventricles
neurons are mitotically active in ____
children
adult neoplasms aoften arise in the _____
supratentorium
cells that adult tumors arise from
astrocytes and oligodendrocytes
childhood neoplams often arise in the _____. give examples
- infratentorium
- might arise in pons, 4th ventricle, cerebellar regions
tumor within the optic nerve is called
optic glioma
tumor pathology is classified based on
biological agressiveness
_______ is a term that denotes lesions that are within the brain parenchyma, in contrast to______, which describes lesions outside the brain
- intra-axial
- extra-axial
intra axial examples
•Intra-axial: Gliomas, Embryonal neoplasms
extra axial examples
•Extra-axial: Meningiomas, Peripheral nerve neoplasms
location of Medulloblastoma
cerebellum
growth pattern of Medulloblastoma
poorly differentiated but well circumscribed, solid mass that enhances without contrast
What do we see here?
Homer wright rosettes in medulloblastoma
locations for Pilocytic astrocytoma (WHO grade I)
Cerebellum
Hypothalamus
Optic nerve
in MRI, contrast enhancement indicatinos disruption of normal ______
blood - brain barrier

pilocytic astrocytoma
common location for ependymoma
- Cerebellum
- Spinal cord

perivascular rosettes characteristic of ependymoma
ependymomas frequently seed the CSF and can form ______
drop metastases
most common brain tumor in adults
meningioma
most common glial cell tumor in adults
glioblastoma
location of diffuse astrocytoma
cerebral hemisphere
common location for glioblastoma
cerebral hemispheres




